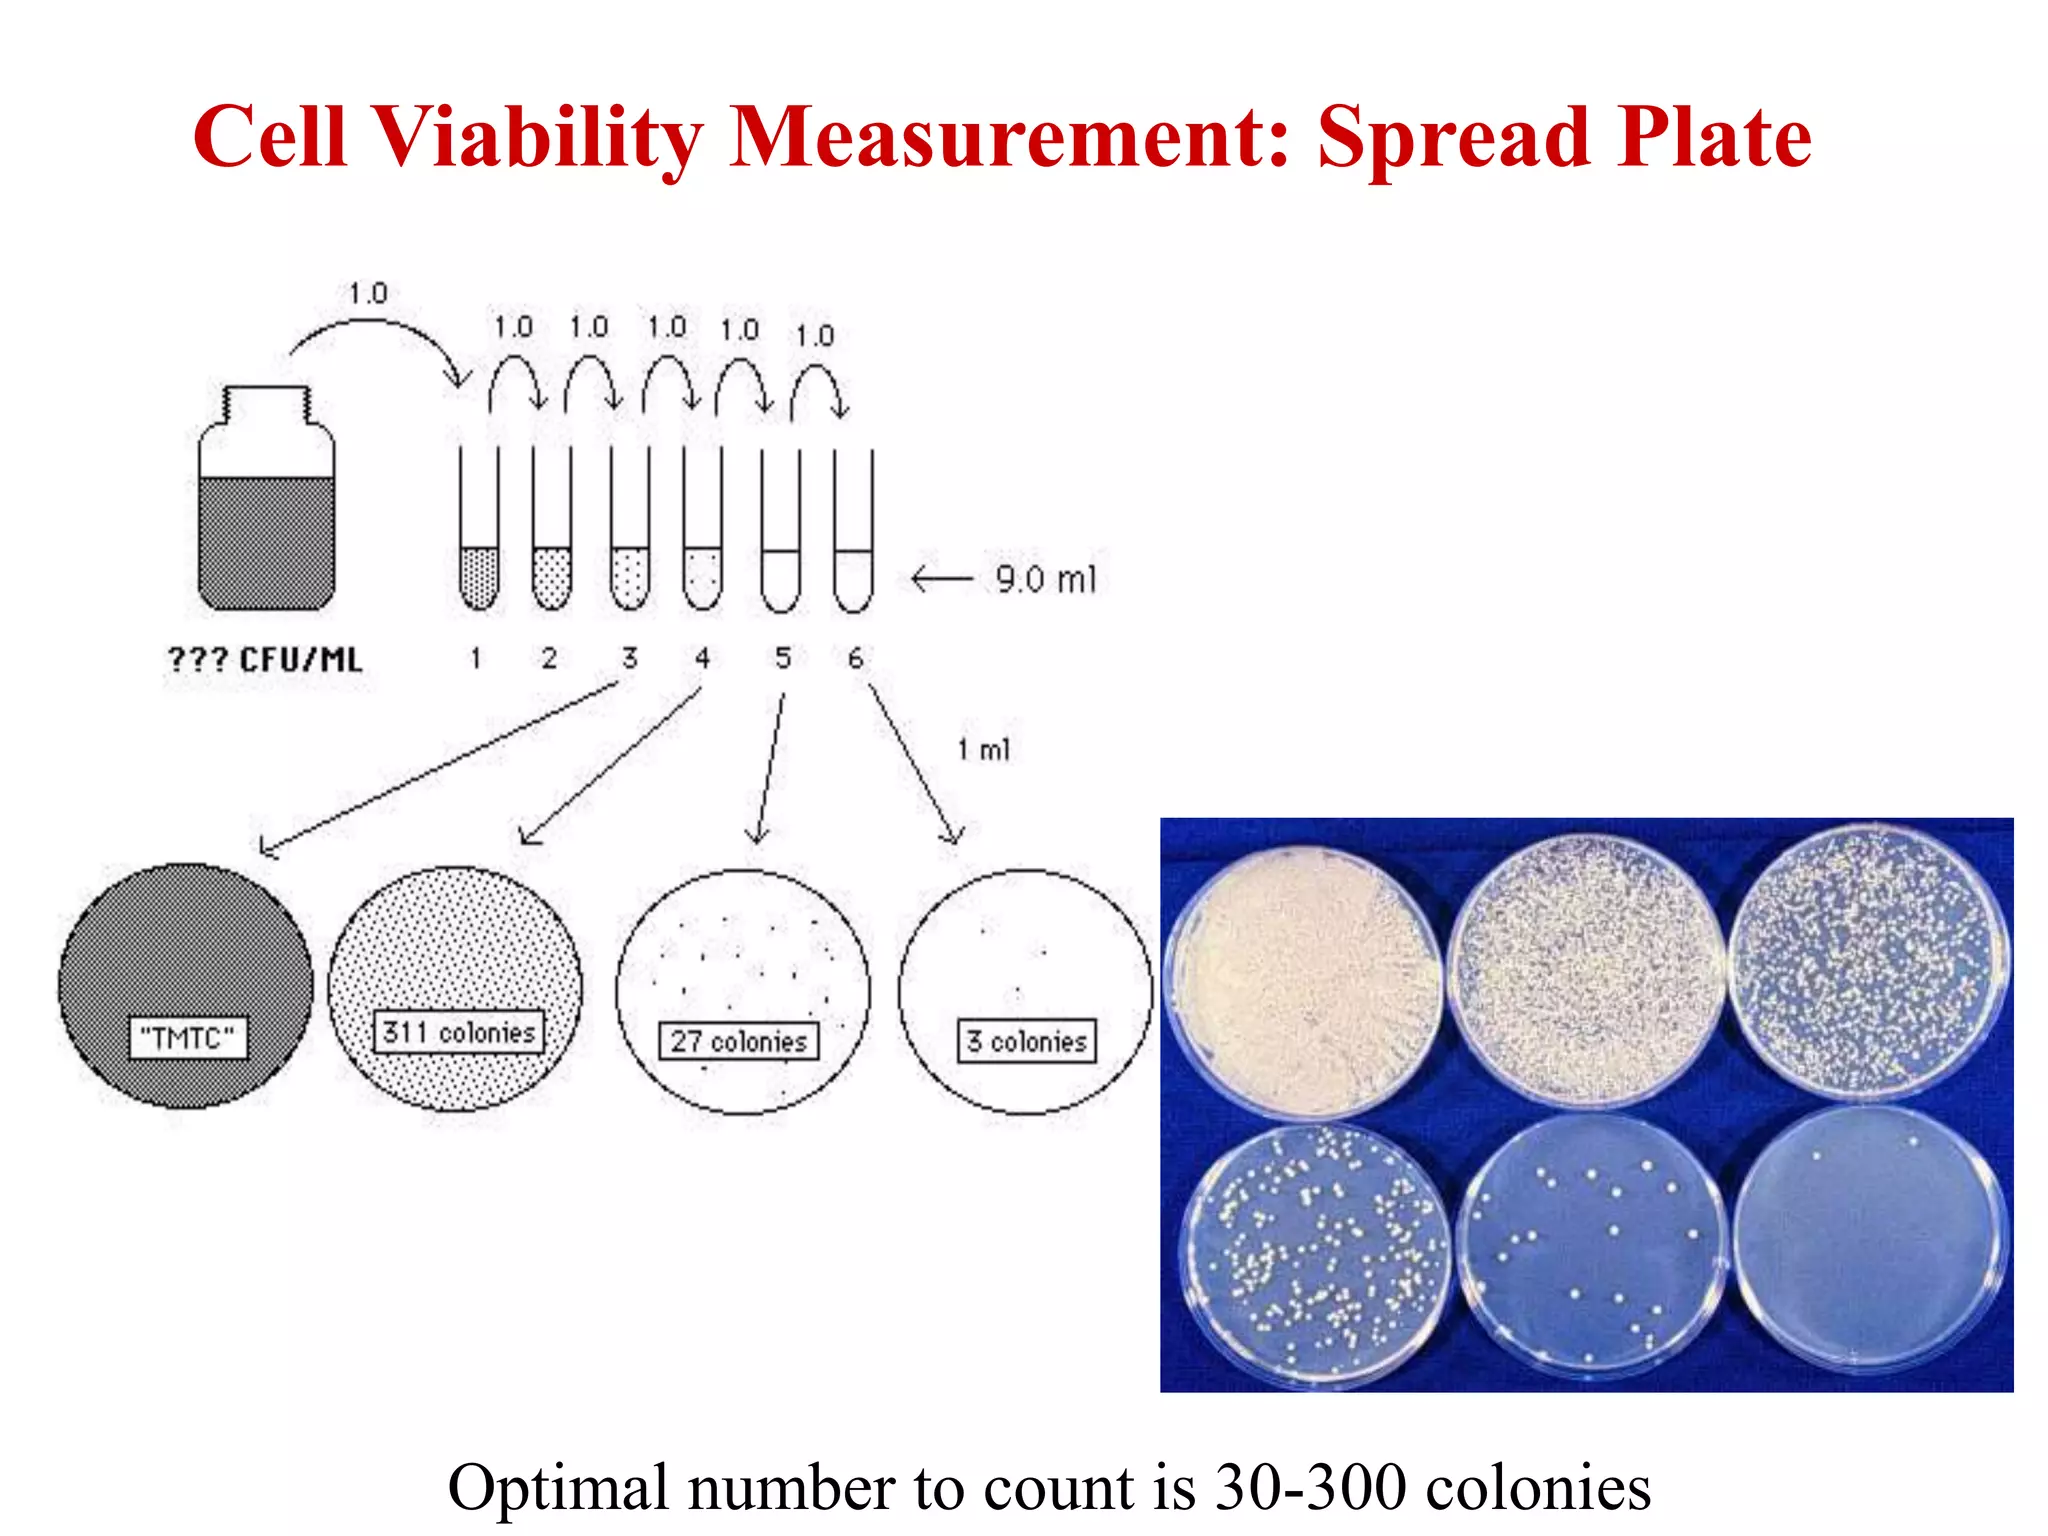
Optimal number to count is 30-300 colonies
Cell Viability Measurement: Spread Plate
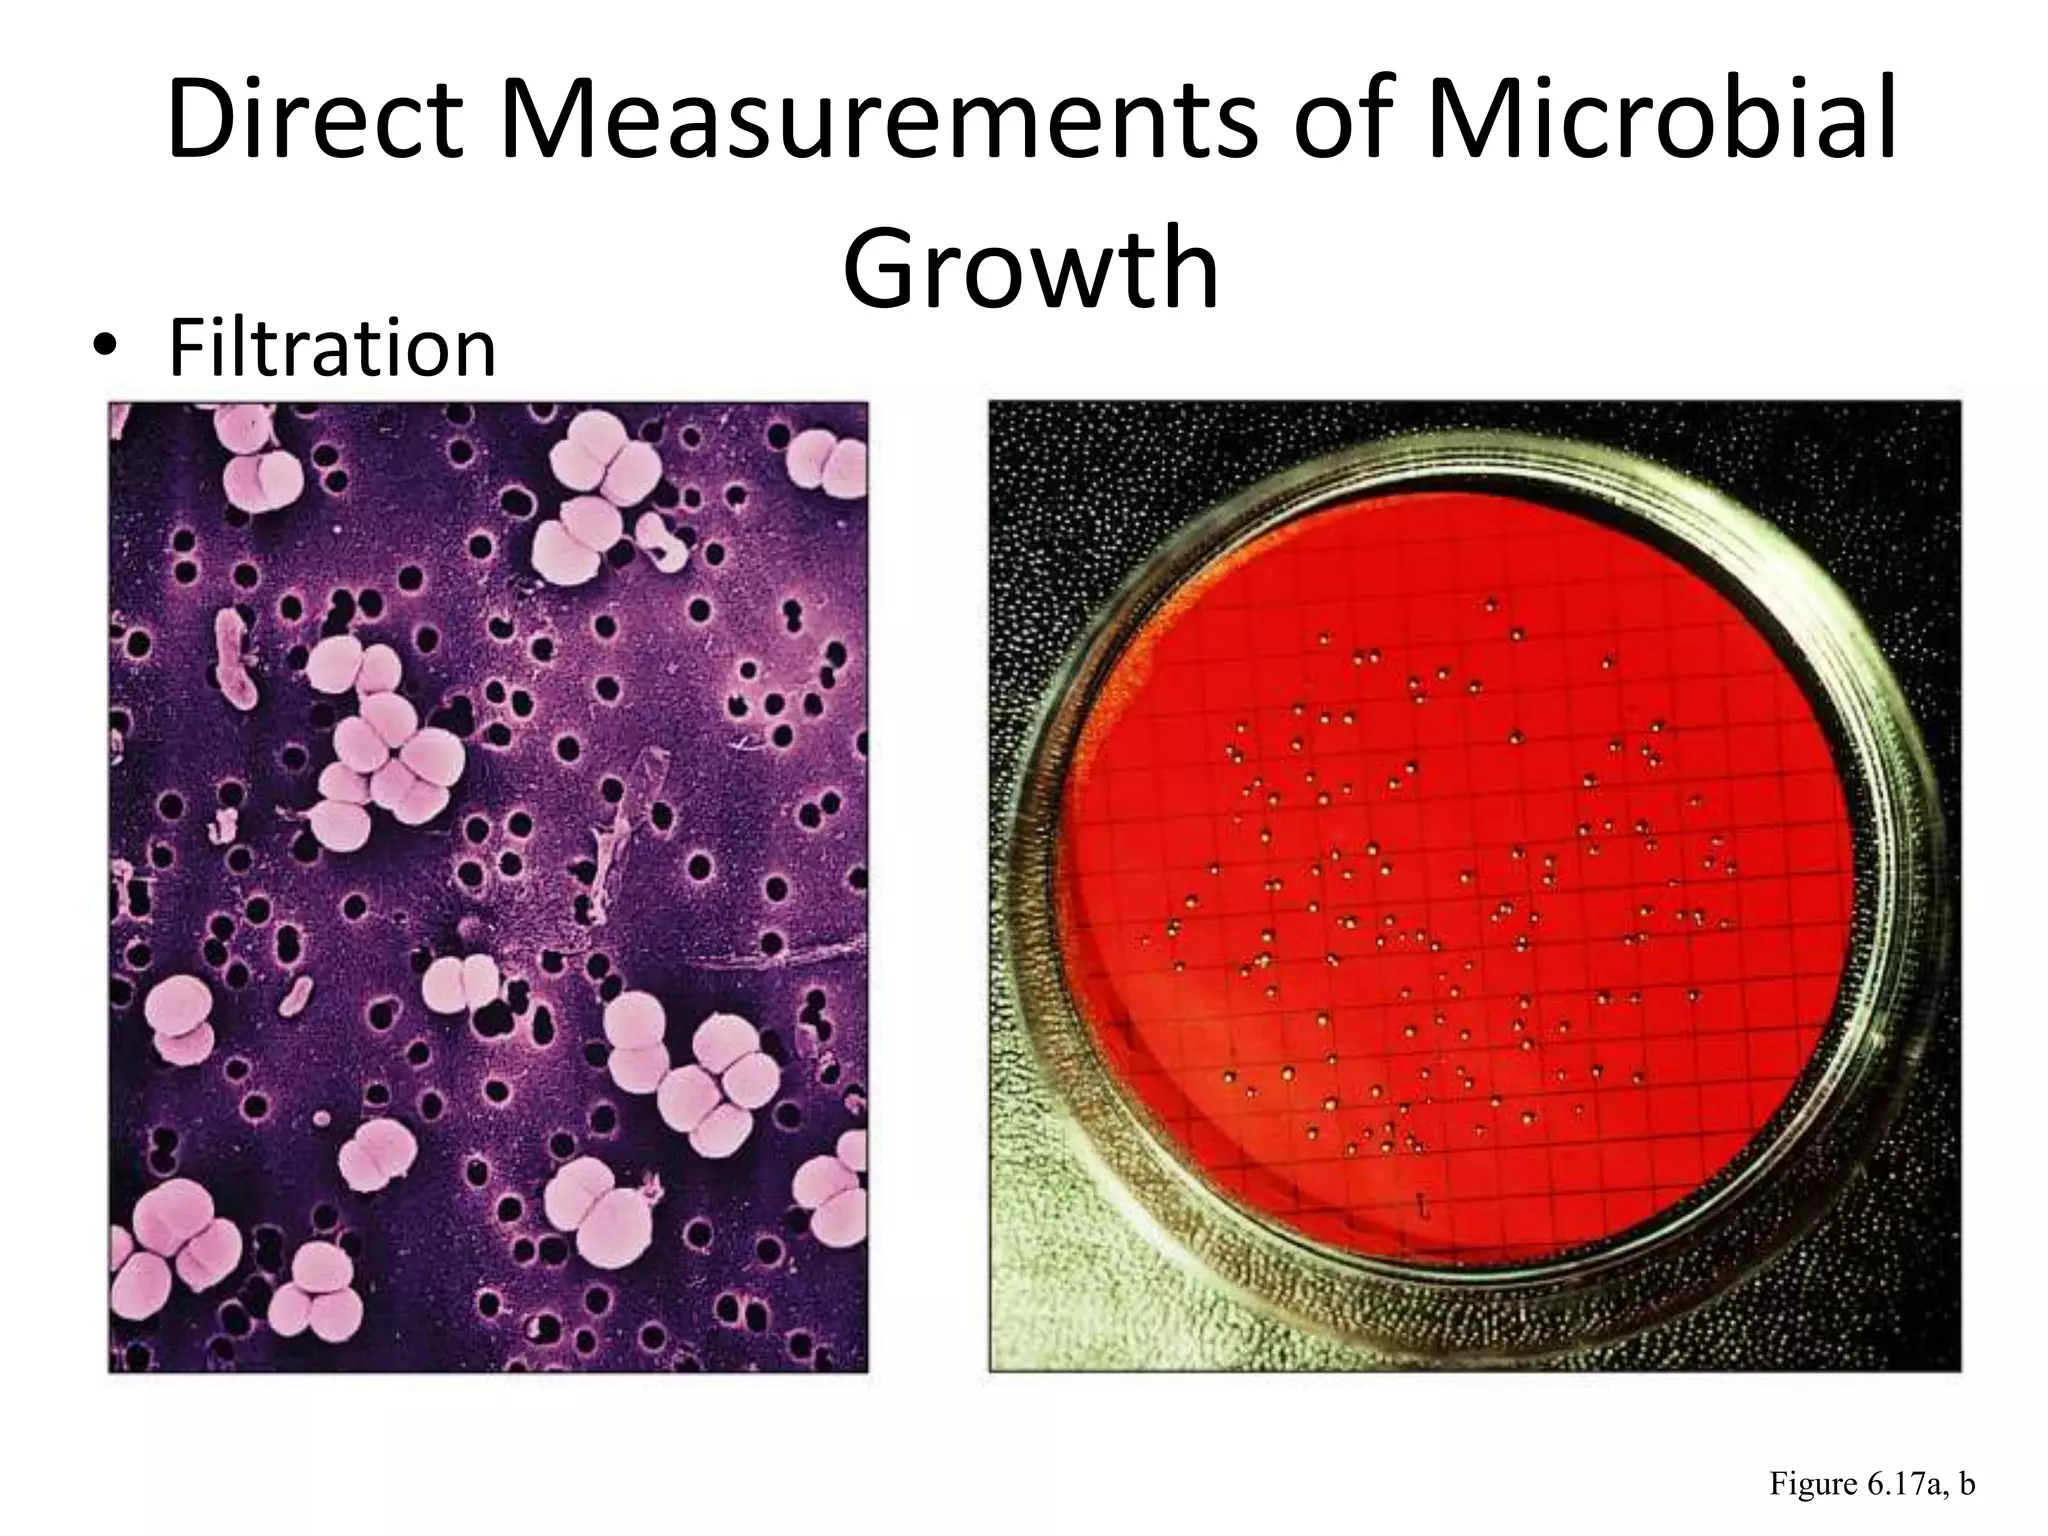
Direct Measurements of Microbial
Growth
• Filtration
Figure 6.17a, b

The document discusses various ways to monitor and measure bacterial growth, including direct and indirect methods. Direct methods involve counting cells directly, such as through plate counts, filtration, or microscopic counts. Indirect methods measure growth factors associated with cells, like turbidity, metabolic activity by products, or dry cell weight. The document provides details on calculations for determining generation time and number of generations from growth curve data.